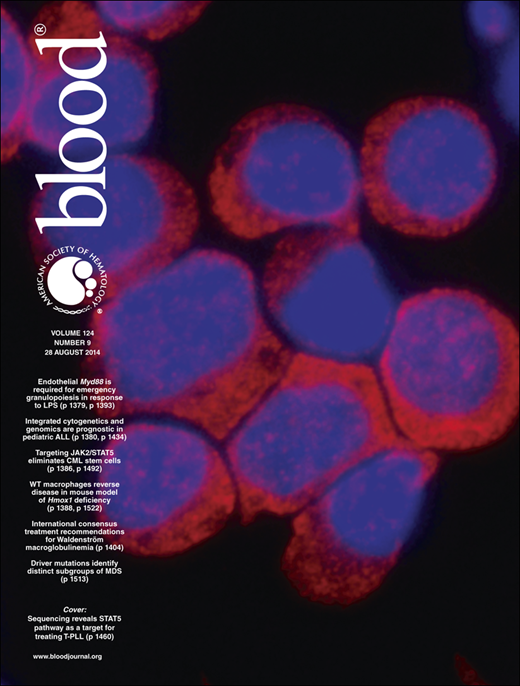

Key Points
Transient BM transplant reverses disease in Hmox1−/− mouse by repopulating tissues with wild-type macrophages capable of recycling heme.
Established donor macrophage populations remain functionally and quantitatively persistent without additional input from hematopoietic tissue.
Abstract
Loss-of-function mutation in the heme oxygenase 1 (Hmox1) gene causes a rare and lethal disease in children, characterized by severe anemia and intravascular hemolysis, with damage to endothelia and kidneys. Previously, we found that macrophages engaged in recycling of red cells were depleted from the tissues of Hmox1−/− mice, which resulted in intravascular hemolysis and severe damage to the endothelial system, kidneys, and other organs. Here, we report that subablative bone marrow transplantation (BMT) has a curative effect for disease in Hmox1−/− animals as a result of restoration of heme recycling by repopulation of the tissues with wild-type macrophages. Although engraftment was transient, BMT reversed anemia, normalized blood chemistries and iron metabolism parameters, and prevented renal damage. The largest proportion of donor-derived cells was observed in the livers of transplanted animals. These cells, identified as Kupffer cells with high levels of Hmox1 expression, persisted months after transient engraftment of the donor bone marrow and were responsible for the full restoration of heme-recycling ability in Hmox1−/− mice and reversing Hmox1-deficient phenotype. Our findings suggest that BMT or the development of specific cell therapies to repopulate patients’ tissues with wild-type or reengineered macrophages represent promising approaches for HMOX1 deficiency treatment in humans.
Introduction
In 1999, the first case of human heme oxygenase deficiency was identified in a Japanese patient who suffered from severe growth retardation, hemolytic anemia with intravascular hemolysis, and paradoxically, increased serum haptoglobin (Hp) and normal bilirubin. Deletions were found in both alleles of HMOX1 in the patient,1 and many of the disease manifestations were comparable with those previously observed in heme oxygenase 1 (Hmox1−/−) knockout (KO) mice.2,3 In both the human patient and the mouse model, renal iron overload was observed, whereas asplenia was diagnosed in patients,1,4,5 and red pulp degeneration developed in aging mice.6 To better understand the shift in tissue iron contents and the pathophysiology of the disease, we studied the Hmox1−/− mice and concluded that loss of functional splenic and hepatic macrophages was the major cause of disease.6 Depletion of splenic macrophages and liver Kupffer cells rendered mice unable to effectively remove senescent red blood cells (RBCs) and hemoglobin (Hb) from the circulation. Our previous in vitro experiments showed that macrophages derived from Hmox1−/− animals could not survive erythrophagocytosis. During hemolysis, Hb binds to the plasma protein Hp, and the complex is subsequently cleared by tissue macrophages that express CD163, the receptor for the Hp–Hb complex.7-9 We found that CD163 expression was dramatically diminished in the reticuloendothelial system of the Hmox1−/− mice. Such impairment of the Hb scavenging system is known to increase Hb toxicity.10,11 Interestingly, depletion of macrophages was observed only in tissues in which macrophages were directly exposed to blood, including splenic red pulp, liver, and bone marrow (BM) sinusoids. The combination of intravascular hemolysis and normal serum bilirubin, which was observed in the first reported human patient,1,5 underscored the relevance of the mouse model to human HMOX1 deficiency. Thus, ineffective recycling of senescent RBCs coupled with impairment of the Hp–Hb clearance system can lead to a cascade of severe damage to endothelial system,12 kidney, and other organs, with a lethal outcome.1,3-5 Genetic background influenced the severity of the phenotype in mice.2,6 Also, 1 patient had no significant health problems until the age of 15 years but died 5 months after presentation.5
Here, we performed subablative BM transplants on Hmox1−/−KO mice and concluded that restoration of a wild-type (WT) macrophage population was sufficient to prevent and reverse disease.
Methods
Animals
Hmox1+/− mice were a generous gift from Anupam Agarwal, from the University of Alabama, Birmingham. The background of these mice is mostly C57BL/6.13 The established colony allowed higher Hmox1−/− birth rates from heterozygote mating pairs than FVB.129S2(B6)-Hmox1tm1Poss/J, available from Jackson Laboratory (stock 008311), in which Hmox1 deficiency causes more severe disease. For the details on original deletion in Hmox1, see Poss and Tonegawa.2 Age- and sex-matched Hmox1+/+ and Hmox1−/− mice were used for the experiments. All animal handling procedures in this study were conducted in accordance with Animal Study Protocol 09-038, approved by the Eunice Kennedy Shriver National Institute of Child Health and Human Development Animal Care and Use Committee.
Blood work
Blood samples were obtained from the tail vein. Complete blood counts were obtained, using a hematology analyzer (Hemavet 1700 FS; Drew Scientific, Waterbury, CT). Hematocrit values were measured by centrifugation of whole-blood samples in capillary tubes. For lactate dehydrogenase (LDH) and alkaline phosphatase (ALP) evaluation, plasma samples (65 μL) from each mouse were analyzed, using a VetAce analyzer (Alfa Wasserman, West Caldwell, NJ).
Histochemistry and immunostaining
Paraffin-embedded mouse tissue sections, as well as hematoxylin and eosin, Perls’ blue, and Masson Trichrome staining, were done by Histoserv, Inc (Germantown, MD).
Macrophages in mouse tissues were identified with F4/80 primary antibody (MCA497R; Serotec), biotinylated goat anti-rat IgG (GR607; Biocare) secondary antibody, 4plus Streptavidin HRP Label (HP604; Biocare), and diaminobenzidine staining, as previously described.14 Hmox1 protein expression in mouse liver was evaluated with monoclonal mouse anti-Hmox1 primary (ab13248; Abcam) and fluorescein isothiocyanate-labeled goat anti-mouse secondary antibodies.
Human liver tissue slides were treated with appropriate dilutions of rabbit anti-HMOX1 (SPC-112 C/D; StressMark Biosciences, Inc.) or mouse monoclonal anti-CD163 (CM353; Biocare Medical). Universal immuno-alkaline-phosphatase polymer Simple Stain AP (MULTI) (414261F; Nichirei Biosciences) was used to label primary antibodies with alkaline phosphatase. Alkaline phosphatase activity was developed with Fast Red TR salt (Sigma-Aldrich).
Preparation of donor BM cells
Quantitative polymerase chain reaction analysis and imaging are presented in the supplemental Methods, available on the Blood Web site.
Results
Nonmyeloablative BM transplantation procedure in Hmox1−/− mice
It is well known that Hmox1 participates in the antioxidant defenses of mammalian cells, and Hmox1-deficient organisms could therefore be highly sensitive to the action of myeloablative treatments such as ionizing radiation and chemotherapeutic drugs. Indeed, preliminary results indicated that Hmox1−/− mice tolerated irradiation poorly (not shown). To avoid high morbidity among Hmox1−/− mice, we chose to prepare animals for BM grafts by using a subablative dose of busulfan (25 mg/kg) delivered in a single intraperitoneal injection 1 day before donor cells were introduced. Use of busulfan as an ablative agent provides a wide window of time for the subsequent introduction of donor materials in mice.15 Donor BM nucleated cells (BMNCs) were extracted from femur and tibial bones of 2- to 3-month-old C57Black/6 mice (CD45.2), and cells were delivered to recipient Hmox1−/− males through tail vein injections. Injections of 20 million BMNCs per 30-g mouse were done on 3 consecutive days, starting the day after the busulfan injection. The cumulative donor-to-recipient ratio was approximately 1:2. The time of the last BMNC injection is referred to as day 0 (Figure 1A). Immunosuppression treatment was maintained for 3 weeks by injecting 3 mg/kg sirolimus intraperitoneally daily, starting from day −3. In a major experiment, from which most of the data reported here were collected, 4 groups of animals were used: Hmox1+/+ mice and Hmox1−/− mice that underwent complete BMT procedure (WT BMT, N = 5; KO BMT, N = 5), and 2 control (Ctr) groups that received neither myeloablative treatment nor donor BMNC injection (WT Ctr, N = 5; KO Ctr, N = 4). All 4 groups were subjected to immunosuppression with sirolimus.
Nonmyeloablative BM transplantation in Hmox1−/− mice improved blood chemistries and led to resolution of anemia. (A) Scheme of the BM transplantation experiment used for subsequent data collection. (B) BM engraftment dynamics are represented as a percentage of CD45.2-positive leukocytes in peripheral blood estimated by fluorescence-activated cell sorter analysis. Changes over weeks are plotted for each individual mouse. (C) Hmox1−/− mice had elevated serum ALP and LDH levels. The blood chemistries returned to normal in BM transplanted recipients. (D) Indicators of microcytic anemia mean cell volume and hematocrit improved in BM-transplanted Hmox1−/− mice. (C-D) Average values for the terminal time, 21 weeks, are shown for each experimental group; error bars represent the standard deviation (N = 5). TMS water, drinking water supplemented with trimethoprim (300 μg/ml) and sulfamethoxazole (60 μg/ml).
Nonmyeloablative BM transplantation in Hmox1−/− mice improved blood chemistries and led to resolution of anemia. (A) Scheme of the BM transplantation experiment used for subsequent data collection. (B) BM engraftment dynamics are represented as a percentage of CD45.2-positive leukocytes in peripheral blood estimated by fluorescence-activated cell sorter analysis. Changes over weeks are plotted for each individual mouse. (C) Hmox1−/− mice had elevated serum ALP and LDH levels. The blood chemistries returned to normal in BM transplanted recipients. (D) Indicators of microcytic anemia mean cell volume and hematocrit improved in BM-transplanted Hmox1−/− mice. (C-D) Average values for the terminal time, 21 weeks, are shown for each experimental group; error bars represent the standard deviation (N = 5). TMS water, drinking water supplemented with trimethoprim (300 μg/ml) and sulfamethoxazole (60 μg/ml).
Engraftment of donor BM was assessed by fluorescence-activated cell sorter analysis of peripheral blood leukocytes that were double-labeled with host-specific CD45.1 and donor-specific CD45.2 antibodies. Blood samples were taken 3, 9, 13, 15, and 21 weeks after the last donor BMNC injection. Three weeks after transplant, each recipient mouse had chimerism of donor white cells in peripheral blood, varying from 22% to 67%, with higher levels of engraftment in WT animals. Most KO BMT animals lost peripheral blood chimerism, whereas WT BMT mice retained significant numbers of circulating donor white cells when the experiment was terminated at 21 weeks (Figure 1B). A 1-year follow-up experiment with slightly different BMT procedures is described in the supplemental Materials.
BMT normalized multiple blood parameters in Hmox1−/− mice
Despite the short period of engraftment in Hmox1−/− mice, the introduction of WT BMNCs reversed abnormal blood biochemistries of BMT recipients. ALP and LDH activities in plasma of Hmox1−/− mice were consistently elevated, so they were chosen as convenient markers to monitor the progression and severity of Hmox1 deficiency disease in live mice. The plasma concentrations for ALP and LDH normalized within 3 weeks of the transplantation and remained normal for as much as 3 months beyond the point when donor cells became undetectable in the peripheral blood of some tested animals (supplemental Figure 1A). At the same time, ALP and LDH activities were 2.4 and 6 times higher, respectively, in the KO Ctr group compared with in the WT Ctr group at the terminal times (Figure 1C). Mean cell volume was also significantly improved at all points tested in KO BMT mice and was, on average, equal to the mean cell volume of transplanted WT mice (Figure 1D). Hematocrits also improved. Although the differences between KO BMT and KO Ctr did not reach statistical significance at the terminal point (Figure 1D), they were statistically significant 3, 9, and 15 weeks after transplantation. Improvement in blood biochemistry in KO BMT mice did not correlate with the number of donor white cells in peripheral blood and was equally sufficient in each individual mouse (supplemental Figure 1A-B). In another experiment, we have proven that blood parameters remained normal as long as 1 year after BMT (supplemental Figure 2A-D).
The pattern of tissue iron distribution normalized in Hmox1−/− transplanted mice
Twenty-one weeks after the BMT, BMT recipients and controls were killed and tissues were studied to evaluate the effects of BMT on tissue pathologies. In the kidney of Hmox1−/− control animals, we observed substantial renal iron accumulations. In addition, iron-positive macrophages were absent from the splenic red pulp, and iron-positive Kupffer cells were absent from livers of untreated Hmox1−/− mice. In contrast, staining for nonheme iron with Perls’ blue stains in the tissues of BMT recipients revealed normalization of iron-staining patterns in the kidneys and livers of transplanted Hmox1−/− animals (Figure 2B-C). Spleen phenotype was only partially restored in such mice. Pockets of functioning red pulp with iron-positive macrophages were found, along with fibrotic areas that lacked macrophages (Figure 2A). While studying the spleens of transplanted animals, we also noticed that prevention of splenic pathology was more effective when the BMT was performed on younger mice, before irreversible collagen accumulation occurred in red pulp (supplemental Figure 2).
BMT normalizes systemic heme-iron recycling and prevents pathological iron accumulation in kidneys. Perls’ stained cross-sections of paraffin-embedded tissues for nonheme iron. Areas of iron accumulation appear in blue. (A) In the spleen, heme-iron recycling macrophages loaded with iron were found throughout the red pulp of WT Ctr, were absent in untreated in KO Ctr, and were partially restored in KO BMT animals. (B) In the liver, iron-positive Kupffer cells were detected in WT Ctr animals (arrows) and were undetectable in untreated KO BMT animals but were present in large numbers in KO BMT animals (arrows). (C) In the kidneys, WT animals lacked iron accumulations, whereas the kidney KO Ctr animals had abnormal iron accumulations in proximal tubules and glomeruli. The kidneys of KO BMT animals appeared normal, consistent with restoration of normal recycling of Hb by donor macrophages in the liver and spleen. Scale bars represent 100 μm (A,C) and 50 μm (B).
BMT normalizes systemic heme-iron recycling and prevents pathological iron accumulation in kidneys. Perls’ stained cross-sections of paraffin-embedded tissues for nonheme iron. Areas of iron accumulation appear in blue. (A) In the spleen, heme-iron recycling macrophages loaded with iron were found throughout the red pulp of WT Ctr, were absent in untreated in KO Ctr, and were partially restored in KO BMT animals. (B) In the liver, iron-positive Kupffer cells were detected in WT Ctr animals (arrows) and were undetectable in untreated KO BMT animals but were present in large numbers in KO BMT animals (arrows). (C) In the kidneys, WT animals lacked iron accumulations, whereas the kidney KO Ctr animals had abnormal iron accumulations in proximal tubules and glomeruli. The kidneys of KO BMT animals appeared normal, consistent with restoration of normal recycling of Hb by donor macrophages in the liver and spleen. Scale bars represent 100 μm (A,C) and 50 μm (B).
An even more striking effect of BMT was observed in the liver, where populations of iron-positive cells, likely representing Kupffer cells, were restored in transplanted Hmox1−/− animals. The iron stains of these putative Kupffer cells suggested that more Kupffer cells were present in the transplanted KO BMT group than in WT Ctr (Figure 2B) and WT BMT (not shown) animals. None of the KO BMT mice showed renal iron deposition (Figure 2C), even in cases when restoration of macrophages to the splenic red pulp appeared to be minimal.
BMT removes oxidative pressure from the kidneys of Hmox1−/− mice
Because of abnormalities of heme recycling in Hmox1−/− mice, the absorption of Hb and free heme increased dramatically in the kidneys.16 In proximal tubules, heme is likely to be metabolized by constitutively expressed Hmox2, and iron released from heme accumulates in ferritin.6,17 Data discussed in the previous paragraph demonstrate that kidney histopathology improved. To assess to what degree renal oxidative stress was reduced, we quantitatively analyzed the expression of several cytoprotective genes that are induced by the Nrf2 transcriptional factor during oxidative stress.18,19 We tested messenger RNA (mRNA) expression coding for the following proteins: inducible glutamine-S-transferases A2 and μ 1 (Gsta2 and Gstm1), the catalytic subunit of the rate-limiting enzyme in glutathione biosynthesis glutamate-cysteine ligase (Gclc), NAD(P)H dehydrogenase, quinone 1 (Nqo1), multidrug-resistance-associated protein 2 (Mrp2), and the iron exporter, ferroportin 1 (Fpn1).18,19 Expression levels of these genes were significantly increased in untreated Hmox1−/− mice, but all remained normal 21 weeks after BMT (Figure 3A-F). The absence of substantial oxidative stress in the kidney of transplanted Hmox1−/− animals suggests that amelioration of disease was significant at the time of the tissues’ collection. Masson trichrome staining for collagen also revealed lesser collagen deposition around the glomeruli of BMT-treated Hmox1−/− mice compared with corresponding mice from the untreated Hmox1−/− control group (Figure 3G). The occasional collagen depositions that were observed in transplanted animals probably occurred before normal heme recycling was restored by the BMT.
BMT reduced the oxidative stress response and prevented injury to Hmox1−/− kidneys. mRNA levels of oxidative stress responsive genes were significantly elevated in KO Ctr animals, including Gsta2 (glutamine-S-transferase A2) (A), Gstm1 (glutamine-S-transferase μ 1) (B), Gclc (glutamate-cysteine ligase, catalytic subunit) (C), Nqo1 [NAD(P)H:quinone dehydrogenase, quinone 1] (D), Fpn1 (ferroportin 1) (E), and Mrp2 (F), but returned to normal after BMT. (G) Masson’s trichrome staining of paraffin-embedded kidney tissues revealed significant accumulation of collagen, which is colored blue (arrows) in KO Ctr mice. Collagen depositions were minimal in transplanted animals. Scale bar represents 50 μm.
BMT reduced the oxidative stress response and prevented injury to Hmox1−/− kidneys. mRNA levels of oxidative stress responsive genes were significantly elevated in KO Ctr animals, including Gsta2 (glutamine-S-transferase A2) (A), Gstm1 (glutamine-S-transferase μ 1) (B), Gclc (glutamate-cysteine ligase, catalytic subunit) (C), Nqo1 [NAD(P)H:quinone dehydrogenase, quinone 1] (D), Fpn1 (ferroportin 1) (E), and Mrp2 (F), but returned to normal after BMT. (G) Masson’s trichrome staining of paraffin-embedded kidney tissues revealed significant accumulation of collagen, which is colored blue (arrows) in KO Ctr mice. Collagen depositions were minimal in transplanted animals. Scale bar represents 50 μm.
Expression of Hmox1 and distribution of donor WT cells in the tissues of transplanted animals
To better understand the mechanisms by which BMT prevented the disease, we compared the expression of Hmox1 in different tissues of transplanted Hmox1−/− animals in comparison with tissues from both WT BMT and WT Ctr groups. BM and splenic expression of Hmox1 were close to 30% of WT BMT, which is quite high considering that the BM engraftments were transient (Figure 4A-B). Surprisingly, expression of Hmox1 mRNA was at least 2 times higher in the livers of transplanted Hmox1−/− animals than in WT groups (Figure 4C). Similarly, a twofold increase in Hmox1 expression was observed 12 months after BMT (supplemental Figure 2E). The highly inducible nature of the Hmox-1 gene makes this high level of expression possible in the presence of inducing agents such as heme, even though relatively small numbers of donor Hmox1+/+ cells are present in the tissues. Interestingly, the kidney, which benefited greatly from the BMT, expressed negligible amounts of Hmox1 mRNA (Figure 4D). These findings support that Hmox1-deficient animals develop pathology as a result of the low heme-recycling capability of their reticuloendothelial systems.6 Removal of Hb and Hp–Hb complexes from the circulation reversed renal pathology, even though Hmox1 expression was virtually undetectable in the kidneys of KO BMT animals.
Hmox1 mRNA expression and quantification of Hmox1+/+ DNA in transplanted Hmox1−/− animals.Hmox1 mRNA expression levels in the tissues of KO BMT animals were partially restored to normal in the BM (A) and spleen (B), were twofold higher in the liver (C), and were negligibly low in the kidney (D) in comparison with WT animals. Data were obtained by quantitative reverse-transcription polymerase chain reaction. ND, not detected. (E) Percentage of WT cells in the tissues of KO BMT animals, as assessed by quantification of the WT Hmox1 gene in a total genomic DNA extracts; we observed that liver had the highest number of donor cells of the 3 key tissues analyzed, at 3%. Primers that target exon 3 of the Hmox1 gene, which was deleted in Hmox1−/− mice, were used for the quantification.
Hmox1 mRNA expression and quantification of Hmox1+/+ DNA in transplanted Hmox1−/− animals.Hmox1 mRNA expression levels in the tissues of KO BMT animals were partially restored to normal in the BM (A) and spleen (B), were twofold higher in the liver (C), and were negligibly low in the kidney (D) in comparison with WT animals. Data were obtained by quantitative reverse-transcription polymerase chain reaction. ND, not detected. (E) Percentage of WT cells in the tissues of KO BMT animals, as assessed by quantification of the WT Hmox1 gene in a total genomic DNA extracts; we observed that liver had the highest number of donor cells of the 3 key tissues analyzed, at 3%. Primers that target exon 3 of the Hmox1 gene, which was deleted in Hmox1−/− mice, were used for the quantification.
To estimate the proportion of the donor WT cells in each of the chimeric tissues, we analyzed total genomic DNA in samples of BM, spleen, and liver of KO BMT mice, using Hmox1-specific primers targeting a portion of the gene that is deleted in the Hmox1−/− mouse.2 Assuming that most of the cells in the analyzed tissues are mononuclear, the proportion of WT Hmox1 genomic DNA indicates the proportion of donor cells in the chimeric tissues. Only 0.5% of the total cells in the BM and spleens of transplant recipients in the KO BMT group carried an intact WT Hmox1 gene and were therefore donor-derived. In the liver, more than 3% of such cells were donor-derived (Figure 4E), which was consistent with higher expression of WT Hmox1 mRNA in this organ (Figure 4A-C).
Hmox1 is highly expressed in WT Kupffer-like cells of mice and humans and is restored in the liver of transplanted Hmox1−/− animals
Our results suggested that the curative effects of transient BMT were attributable to the presence of relatively large number of donor cells with high level of Hmox1 expression in the liver of KO BMT mice. To see whether this result was achieved by restoring macrophage populations, we investigated the localization of Hmox1 protein within the livers of transplanted Hmox1−/− mice (KO BMT). Immunofluorescence on paraffin-embedded hepatic tissue sections revealed that Hmox1 was expressed in Kupffer cell-like patterns in WT Ctr and WT BMT mice, whereas relatively insignificant levels of Hmox1 expression were observed in hepatocytes (Figure 5A, left). No specific signal was detected in livers of Hmox1−/− animals (Figure 5A, upper right). In the livers of the KO BMT mice, Hmox1-positive cells in a Kupffer cell-like pattern were present in greater numbers than in WT controls (Figure 5A, bottom). This increase of Hmox1-expressing cells agreed with the quantitative reverse-transcription polymerase chain reaction data, which showed a doubling of expression of Hmox1 in the livers of KO BMT group in comparison with the WT BMT and WT Ctr groups (Figure 4C).
Comparison of Hmox1 protein expression in mouse and human liver tissue of controls with Hmox1-deficient animals and patient samples. (A) Cross-sections of paraffin-embedded liver tissue immunofluorescence showed that Kupffer cells were a major site of Hmox1 expression in both WT Ctr and WT BMT mice (left); no specific Hmox1 signal was detectable in the liver KO Ctr animals (upper right); an Hmox1-expressing Kupffer cell population was restored in the liver of transplant recipients (bottom right). Arrows point to Hmox1-positive cells. (B) A human liver biopsy specimen obtained from human with intact HMOX1 gene showed high HMOX1 signal present in Kupffer-like cells (left), whereas there was no HMOX1 expression in the liver sample of an HMOX1-deficient patient specimen (right). Scale bars represent 50 μm (A) and 25 μm (B).
Comparison of Hmox1 protein expression in mouse and human liver tissue of controls with Hmox1-deficient animals and patient samples. (A) Cross-sections of paraffin-embedded liver tissue immunofluorescence showed that Kupffer cells were a major site of Hmox1 expression in both WT Ctr and WT BMT mice (left); no specific Hmox1 signal was detectable in the liver KO Ctr animals (upper right); an Hmox1-expressing Kupffer cell population was restored in the liver of transplant recipients (bottom right). Arrows point to Hmox1-positive cells. (B) A human liver biopsy specimen obtained from human with intact HMOX1 gene showed high HMOX1 signal present in Kupffer-like cells (left), whereas there was no HMOX1 expression in the liver sample of an HMOX1-deficient patient specimen (right). Scale bars represent 50 μm (A) and 25 μm (B).
To evaluate the pattern of HMOX1 expression in normal human liver, we performed immunohistochemistry for HMOX1 and demonstrated that HMOX1 expression was high in Kupffer-like cells, whereas HMOX1 expression was much lower in surrounding hepatocytes (Figure 5B, left). These results suggest the importance of HMOX1 expression in liver macrophages under steady-state conditions.
BMT restored the Kupffer cell population in Hmox1−/− mice
We explored whether the population of Kupffer cells was restored in the liver sinusoids of Hmox1−/− mice after BM transplantation. Using the antibody to the F4/80 antigen, a membrane protein whose expression is restricted to mature tissue, we found significant numbers of Kupffer cells in the livers of transplanted Hmox1−/− mice (Figure 6A). Unlike in the spleen, where restoration of iron-recycling macrophages depended on the age of transplanted animals, liver Kupffer cells appeared to be completely restored regardless of the age at which recipients received transplants. The large numbers of Kupffer cells in the liver of transplanted animals were apparently sufficient to support RBC recycling, even when the splenic red pulp was replaced by tissue fibrosis and was minimally repopulated with macrophages.
Kupffer cells are absent in the livers of Hmox1−/− animals and a human patient, but BMT restores Kupffer cells to Hmox1−/− mice. (A) Immunohistochemistry for the pan-macrophage marker, F4/80, indicated that Kupffer cells were virtually absent in the livers of Hmox1−/− sham mice (upper middle and right) in comparison with WT mice (left). F4/80-positive cells turned brown after diaminobenzidine staining (arrowheads). BMT completely restored macrophage populations in Hmox1−/− animals (lower middle and right). Results are shown for Hmox1−/− animals that were 4 months (middle) or 1.7 months (right) old at the time the BMT procedure was performed. (B) Expression of the marker of M2 polarized macrophages indicated that CD163 was partially restored in liver, BM, and spleen of KO BMT mice, as determined by quantitative reverse-transcription polymerase chain reaction. ND, not detected. (C) CD163 Kupffer cells normally found in human liver (left) were undetectable in the liver of an HMOX1-deficient patient (right). Scale bars represent 50 μm (A) and 25 μm (C).
Kupffer cells are absent in the livers of Hmox1−/− animals and a human patient, but BMT restores Kupffer cells to Hmox1−/− mice. (A) Immunohistochemistry for the pan-macrophage marker, F4/80, indicated that Kupffer cells were virtually absent in the livers of Hmox1−/− sham mice (upper middle and right) in comparison with WT mice (left). F4/80-positive cells turned brown after diaminobenzidine staining (arrowheads). BMT completely restored macrophage populations in Hmox1−/− animals (lower middle and right). Results are shown for Hmox1−/− animals that were 4 months (middle) or 1.7 months (right) old at the time the BMT procedure was performed. (B) Expression of the marker of M2 polarized macrophages indicated that CD163 was partially restored in liver, BM, and spleen of KO BMT mice, as determined by quantitative reverse-transcription polymerase chain reaction. ND, not detected. (C) CD163 Kupffer cells normally found in human liver (left) were undetectable in the liver of an HMOX1-deficient patient (right). Scale bars represent 50 μm (A) and 25 μm (C).
In addition to erythrophagocytosis of senescent RBCs, reticuloendothelial macrophages scavenge Hb released directly into the circulation from damaged RBCs. Free Hb forms complexes with serum protein Hp, which is synthesized and secreted by hepatocytes.20 A subset of tissue macrophages known as alternatively activated (M2) macrophages21 are the only cells in the mouse that express significant amounts of the Hp–Hb complex scavenging receptor, CD163 (also known as ED2).22-24 CD163 mRNA expression was very low in the BM, spleens, and livers of Hmox1−/− animals, and the clearance of released Hb from the bloodstream of these animals was minimal. We found significantly increased CD163 expression in the KO BMT group in comparison with KO Ctr (Figure 6B). The significant increase of CD163 levels in BM was particularly interesting, as this protein has been implicated in macrophage-erythroblast interaction in erythroblastic island and in promoting erythropoiesis. Thus, the restoration of CD163-expressing macrophages may ameliorate the previously unexplained anemia in Hmox1−/− animals by providing a supportive environment for effective erythropoiesis.23,25
To explore whether our conclusions about the loss of CD163+ macrophages were relevant to the pathophysiology of Hmox1−/− deficiency disease in humans, we analyzed patient liver samples obtained at autopsy from a patient with HMOX1 deficiency.3 In this patient, a paradoxical increase in the serum Hp concentration occurred in parallel with increased hemolysis, whereas Hp levels usually drop in the circulation during hemolysis because Hp–Hb complexes are removed from the circulation by CD163+ macrophages. We found no detectable CD163+ cells in the liver of the patient (Figure 6C, right), whereas there were ample CD163+ cells in normal human liver tissue (Figure 6C, left), consistent with our findings in the Hmox1−/− mouse model. These results suggested that loss of macrophages that can internalize and degrade Hp–Hb complexes was also an important feature that contributed to the pathophysiology of the first patient described and may also be important in disease progression in several newly discovered cases.4,5
Our findings demonstrate that a human HMOX1-deficient patient had few or no surviving macrophages in the liver. The pathologic findings in the human patient resembled findings in Hmox1−/− mice, but the human patient had more severe anemia, hemolysis, and renal and endothelial tissue damage than our Hmox1−/− mice. However, Hmox1−/− mice were previously bred onto different backgrounds to increase their survival, and our strain of Hmox1−/− mice is not as severely ill as some other strains, likely because of selection for unknown genetic modifiers that enhance survival.2
Discussion
We previously analyzed the pathophysiology and iron distribution of Hmox1−/− mice6 and concluded that much of their disease was caused by their inability to process large boluses of Hb acquired by individual macrophages during erythrophagocytosis. We demonstrated that heme toxicity led to the death of Hmox1−/− erythrophagocytosing macrophages in vitro. High levels of circulating nonmetabolized heme in the blood also led to increased renal iron accumulation and fibrotic scarring from heme and iron toxicity in the kidney. The clear relevance of the mouse model to human disease led us to hypothesize that BM transplantation could restore functional macrophages, and thereby prevent or ameliorate disease progression in the animal model, paving the way for treatment of HMOX1-deficient patients who have been diagnosed more recently.4,5 Initially, we attempted to perform ablative BM transplants in Hmox1−/− mice, but the toxicity was too great for these sensitive mice, so we switched to performing subablative BM transplants, which have been shown to be efficacious in patients with sickle cell disease and other diseases in which thresholds are important.26,27
Our subablative BM transplantation treatment restored macrophages in the liver, and partially to portions of the spleen that were nonfibrotic. The renal iron accumulation and oxidative stress were completely eliminated. Serum LDH and ALP levels returned to normal, and the mild anemia of Hmox1−/− animals resolved. Even though the BM transplants were subablative and the number of circulating donor white cells dropped significantly during the weeks of the experiment, we discovered that donor-derived cells populated the liver with Kupffer cells, repopulated unscarred areas of the spleen, and also populated the BM, remaining detectable and active months after the donor BM-derived neutrophils and monocytes were lost. In mice that were treated within 7 weeks after birth, we observed the greatest recovery of spleen morphology, whereas extensive scarring appeared to have obliterated the red pulp niche and prevented repopulation by donor macrophages in older mice. Given that the residual BM donor population was low, whereas tissue Kupffer cell expression remained robust and higher than in WT many months after transplant, our results are compatible with recent studies that demonstrate that tissue macrophage populations can self-renew and maintain functional capability during long periods of time (reviewed in Takahashi28 and Sieweke and Allen29 ).
The prevailing view that tissue macrophages are derived from circulating monocytes has been significantly revised during the last several years. Fate-mapping studies revealed that continuously self-renewing tissue macrophages derived from the embryonic yolk sac were distributed to multiple tissues before the onset of definitive hematopoiesis.30 These macrophages represent an example of a fully differentiated cell type that can self-renew during an extended period of time without passing through pluripotent stem cell intermediate stages.31 Our study suggests 3 possibilities that allow sufficient numbers of macrophages to persist after brief transient engraftment: donor monocyte-derived cells can become mature polarized macrophages that can self-renew through multiple cell cycles,32 the initial BM injection provided enough cellular material to establish WT stem cell or macrophage progenitor cell populations directly in the liver of Hmox1−/− animals, or mature and active tissue macrophages can survive for at least 1 year. Any of these 3 scenarios could explain how differentiated macrophages persist in the liver long after WT monocytes have disappeared from the peripheral blood of transplanted animals.
We suggest that a key to the apparent success of our treatment is attributable to the highly inducible nature of the Hmox1 gene, which enabled donor macrophages to greatly amplify their ability to catabolize Hb. Although only 3% of total liver cells and 0.5% of BM and spleen cells were of donor origin, Hmox1 expression levels in Hmox1−/− donor recipients were comparable to those in WT animals. Remarkably, the liver expression of Hmox1 mRNA in transplanted knockouts was twofold increased compared with WT animals, at both 5 (Figure 4C) and 12 (supplemental Figure 2E) months after BMT.
Macrophage-like cells were the major site of Hmox1 protein expression in the livers of WT and KO BMT mice and human liver samples. The repopulation of KO livers with Kupffer cells supported that the curative effect of BMT on Hmox1−/− mice was mediated by repopulation of reticuloendothelial system with WT macrophages. Hmox1+/+ macrophages enabled the system to recycle RBCs and to prevent damage from intravascular hemolysis. The high efficiency with which WT macrophages repopulated livers of Hmox1−/− mice and the stability of this population months after loss of circulating donor-derived cells is an important phenomenon that enhances the likelihood that BMT will help patients.
Stable improvement of the anemia characteristic of Hmox1−/− mice after transient engraftment of WT BM is an unexpected outcome of our study. Although WT cells represent only around 0.5% of all BM cells in transplanted Hmox1−/− animals, hematocrit levels improved significantly and were similar to those in WT animals that underwent BMT procedure. The mean corpuscular volume also returned to normal. Interestingly, CD163 expression was restored in the BM s of transplanted Hmox1−/− animals, pointing to at least partial restoration of the macrophage population in BM. It has been previously shown that CD163 is particularly highly expressed on the surface of erythroblastic island macrophages, where its expression mediates adhesion of erythroblasts and promotes their growth and survival.23 The improvement in the health of the macrophages in erythroblastic islands of the BM was likely one of the reasons the anemia resolved. The resolution of the anemia may depend on the importance of macrophages in the formation of erythroblastic islands and the creation of a favorable environment for hematopoiesis. In a mouse model, chemical depletion of macrophages was recently shown to reduce erythropoiesis and induce anemia.33
Although HMOX1 deficiency disease in humans has some distinctive features, including severity of the disease in its acute phase and severe endothelial injury, the mechanism of its development lies in the inability to efficiently catabolize heme from RBCs, and the mouse model is highly relevant to understanding the pathophysiology of the disease. Immunohistostaining of the liver from a HMOX1-deficient patient revealed no CD163-positive macrophages, as our results from the mouse model predicted. The absence of macrophages from the patient’s liver indicates the importance of the HMOX1 enzyme for the survival of these cells. We anticipate that similar beneficial effects could be realized with BMT on human patients, particularly when siblings are available to supply donor material. Now that the pathognomonic triad of intravascular hemolysis coupled with high serum Hp and normal bilirubin has been recognized to result from Hmox1 deficiency in humans and mice, more patients may acquire their diagnosis through sequencing of the HMOX1 gene. Such patients could be offered a new treatment, using subablative BM transplantation to reconstitute their reticuloendothelial systems, which should prevent most of the disease manifestations. Recent developments in gene therapy, induced pluripotent stem cell, and other cell reprogramming technologies open multiple opportunities for the development of new effective treatments for HMOX1-deficient patients.34-38
The online version of this article contains a data supplement.
There is an Inside Blood Commentary on this article in this issue.
The publication costs of this article were defrayed in part by page charge payment. Therefore, and solely to indicate this fact, this article is hereby marked “advertisement” in accordance with 18 USC section 1734.
Acknowledgment
This work was supported by the Eunice Kennedy Shriver National Institute of Child Health and Human Development intramural program, by the National Institute of Heart Lung and Blood Disorders, and the Division of Veterinary Resources, Office of Research Services, Office of the Director, National Institutes of Health, Bethesda, MD.
Authorship
Contribution: G.K. designed research, performed most experiments, analyzed data, and wrote the paper; M.C.G., M.A.E., W.O., and A.Y. performed experiments and analyzed data; R.P.W. and J.F.T. designed experiments and analyzed data; and T.A.R. oversaw the study, designed research, analyzed data, and wrote the paper.
Conflict-of-interest disclosure: The authors declare no competing financial interest.
Correspondence: Tracey Rouault, Molecular Medicine Program, Eunice Kennedy Shriver National Institute of Child Health and Human Development/NIH, 35 Convent Dr, MSC3755, Bethesda, MD 20892; e-mail- rouault@mail.nih.gov.



![Figure 3. BMT reduced the oxidative stress response and prevented injury to Hmox1−/− kidneys. mRNA levels of oxidative stress responsive genes were significantly elevated in KO Ctr animals, including Gsta2 (glutamine-S-transferase A2) (A), Gstm1 (glutamine-S-transferase μ 1) (B), Gclc (glutamate-cysteine ligase, catalytic subunit) (C), Nqo1 [NAD(P)H:quinone dehydrogenase, quinone 1] (D), Fpn1 (ferroportin 1) (E), and Mrp2 (F), but returned to normal after BMT. (G) Masson’s trichrome staining of paraffin-embedded kidney tissues revealed significant accumulation of collagen, which is colored blue (arrows) in KO Ctr mice. Collagen depositions were minimal in transplanted animals. Scale bar represents 50 μm.](https://ash.silverchair-cdn.com/ash/content_public/journal/blood/124/9/10.1182_blood-2014-02-554162/4/m_1522f3.jpeg?Expires=1769624104&Signature=xBdwDjhDapz4tUSbxY3li4ucW-lYNWzhs-WPwQNxDHlct~myGlmDeOw0rK7TXfWV8~n1lBYM~PTc59ZOaJhNPF7LicPzsdaXjByVsw1A-QijZ9IF~td4aQvRn5LBZujuHgbdELkmhrliWNMJI3ot~PDoYEFa-qdEl~To9YYGAUbzt4pc-bmPT4r~nusIg81boxyMurLVxzE5YAZsEqs4deYxaA1YetR-t71gL~E8PApc2FYuBHMSwFIJOqb6ihR4qM5ruy6ncoyViBmTCpFELrktYa66guYT72odJ6S0w6K8~L~4ZoGG4Wqb13yBKtc1RsseBUmrxAc35I5BX0a4uQ__&Key-Pair-Id=APKAIE5G5CRDK6RD3PGA)